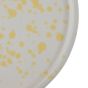
BOOGY SPLASH - πιάτο κεραμικό πρωινού 21cm, κίτρινο

BOOGY SPLASH - πιάτο κεραμικό πρωινού 21cm, κίτρινο
BOOGY SPLASH
πιάτο κεραμικό πρωινού 21cm, κίτρινο
9,99 €
Περιλαμβάνει Φ.Π.Α.
Κωδικός Προϊόντος: 000000001000510896
Ημέρες Παράδοσης: Από 2 εώς 5 εργάσιμες ημέρες
Ζωντανές πινελιές με χρώμα χορεύουν στο πιάτο πρωινού BOOGY SPLASH. Αυτό το μινιμαλιστικό σερβίτσιο από υψηλής ποιότητας κεραμικό, διαθέτει οργανικό σχήμα και, σε μια μοντέρνα εκδοχή, θυμίζει το στρογγυλεμένο σχήμα ενός φρίσμπι. Αυτή η ξεχωριστή εμφάνιση, σε συνδυασμό με την ουδέτερη χρωματική παλέτα, καθιστά τα πιάτα και τα μπολ της συλλογής BOOGY SPLASH εντυπωσιακά κομμάτια σε κάθε τραπέζι. Διατίθεται σε ποικιλία χρωμάτων, ιδανικά για να δημιουργήσετε το δικό σας μοναδικό συνδυασμό.
Ζωντανές πινελιές με χρώμα χορεύουν στο πιάτο πρωινού BOOGY SPLASH. Αυτό το μινιμαλιστικό σερβίτσιο από υψηλής ποιότητας κεραμικό, διαθέτει οργανικό σχήμα και, σε μια μοντέρνα εκδοχή, θυμίζει το στρογγυλεμένο σχήμα ενός φρίσμπι. Αυτή η ξεχωριστή εμφάνιση, σε συνδυασμό με την ουδέτερη χρωματική παλέτα, καθιστά τα πιάτα και τα μπολ της συλλογής BOOGY SPLASH εντυπωσιακά κομμάτια σε κάθε τραπέζι. Διατίθεται σε ποικιλία χρωμάτων, ιδανικά για να δημιουργήσετε το δικό σας μοναδικό συνδυασμό.